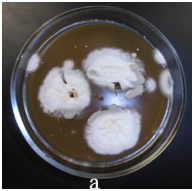

Journal of
eISSN: 2469 - 2786


Case Report Volume 2 Issue 5
1Department of Clinical Mycology, Allergology and Immunology, North-Western State Medical University, Russia
2SM Kirov Military Medical Academy, Russia
Correspondence: Sofya N Khostelidi, Department of Clinical Mycology, Allergology and Immunology, North-Western State Medical University named after II Mechnikov, 194291, Santyago de Cuba str, Build 1/28 Saint-Petersburg, Russia, Tel 78123035146
Received: June 30, 2016 | Published: October 4, 2016
Citation: Klimko NN, Khostelidi SN, Melekhina YE, et al. Acremonium pneumonia successfully treated in patient with acute myeloid leukemia: a case report. J Bacteriol Mycol Open Access. 2016;2(5):116-119. DOI: 10.15406/jbmoa.2016.02.00036
Invasive fungal infection is a major cause of morbidity and mortality in patients who receive treatment for acute myeloid leukemia (AML). We present the case of successful treatment of Acremonium spp. pneumonia in patient with acute myeloid leukemia who underwent chemotherapy.
Keywords: mycotic pneumonia, Acremonium spp., acute myeloid leukemia, voriconazole
Fungal infection remains a significant cause of morbidity and mortality in patients with AML. Moreover, there has been an increase of the fungal infections incidence caused by moulds such as Mucorales, Fusarium and Scedosporium1 and other rare micromycetes.2 There is a paucity of the literature data devoted to mycotic pneumonia caused by Acremonium spp. in patients with AML. Acremonium infection is difficult to diagnose. It is necessary to distinguish airway colonization and involvement of lung tissue. This case report also highlights the difficulties in diagnosing invasive pulmonary mycosis (caused by Acremonium spp.) and the importance of correct antifungal therapy.
In February 2013 a 78-year-old man with AML was hospitalized to the Hematology department of Military Medical Academy (St. Petersburg, Russian Federation) for induction chemotherapy. The patient had (in the first day of chemotherapy) leukocytes - 45,7*109/L, blasts-37.5%, granulocytes-1%. The cytoreductive therapy was started with hydroxycarbamide (dose 1-3g). The result-partial clinical and hematological remission. The patient had neutropenia throughout the treatment period (14days).
On the 10th day after admission, the patient presented fever (38.5-39.0°C) without any additional clinical signs (day 0), while white blood cells (WBC) count was 400/ml with zero neutrophil per ml. The patient was treated with small doses of cytosar. Fever persisted with the onset of a dry cough and impaired general condition.
The computed tomography (CT) scans of the chest showed interstitial infiltrates in the right lower lung. Galactomannan test (Platelia Aspergillus, Bio-Rad) in serum was negative. The patient was treated empirically by ceftriaxone 6 g/day and amikacin 1.5g/day. After 3days of continuous high fever, the antibiotic therapy was changed to imepenem 2.0g/day and linezolid 1.2g/day for 10days.
Due to the progression of infection in the right lung, the patient was treated empirically by caspofungin 50mg/day. On day +14 his condition worsened (dyspnea was growing) and he was transferred to ICU. He had persistent pyrexia despite treatment with imepenem, linezolid, and caspofungin. The CT scans of his chest were repeated and revealed a large abscess in the right lower lung. CT of the chest at 14th day revealed interstitial infiltrates with abscess in the right lower lobe (Figure 1).

The bronchoscopy and transbronchial biopsy of the lung lesions were performed. Septate mycelium was found by microscopy of the bronchoalveolar lavage (BAL) and lung tissue histology. Abundant growth of moulds was received. The material was sent to the P.Kashkin Research Institute of Medical Mycology at I.Metchnikov North-Western State Medical University for the identification of species. The obtained fungal culture was identified as Acremonium spp. Growth of Acremonium spp culture was also received from the lung tissue samples (Figure 2).
Other tests, which included blood cultures, respiratory viral PCR, culture and PCR for Mycobacterium tuberculosis in BAL samples, were all negative.
On the basis of this investigation mycotic pneumonia (agent - Acremonium spp.) was diagnosed. Antimycotic therapy was changed to oral voriconazole 200mg twice daily. The outcome was favorable. On April 15, 2013 white blood cell count was restored (2.4 х 109/L) by colony-stimulating factor. The total duration of agranulocytosis, from the first day of treatment, was 48days.
After 7days of voriconazole therapy the patient had a marked improvement in his general health condition (no fever or cough). After 3month of antifungal treatment by CT was noted complete resolution of the mycotic pneumonia (Figure 3).
The total duration of antimycotic therapy was 130days. Later, the patient was treated with voriconazole for secondary prophylaxis on each course of chemotherapy. He was still alive and in complete remission of mycotic pneumonia in a 6-months follow-up.
Acremonium spp. is a genus of fungi, formerly known as Cephalosporium, in the phylum Ascomycota, Hypocreales order, Hypocreaceae family. Acremonium spp. has a worldwide distribution, it is commonly found in the environment in soil and on dead plant material as well as in hay and rotting plants; some species can be also found in food stuff.1–3 Acremonium is a large polyphyletic fungal genus that comprises approximately 150 species. Most species of Acremonium are saprophytic and non-pathogenic. However, certain species are pathogenic to plants and humans. Species that have been reported to cause infections in humans are Acremonium alabamensis, Acremonium kiliense (now Sarocladium kiliense), Acremonium roseogriseum (now Gliomastix roseogrisea), Acremonium strictum (now Sarocladium strictum), Acremonium potronii and Acremonium recifei. The species of Acremonium are morphologically very similar to each other and can be distinguished only by subtle differences, which makes their identification difficult. Therefore, in most of the clinical cases the etiological agent was reported only as Acremonium sp. that expanding the list of the Acremonium genus possible pathogens.1–3
Acremonium spp. penetrate to macroorganism mainly through damaged skin or mucous membranes usually causing mycetoma or keratitis.4–6 In immunocompromised patients micromycetes can penetrate not only through lesions (which can appear as results of injury or maceration of the skin in places of catheter fixation), but also via inhalation affecting paranasal sinuses and lungs with further spreading of infection. In the published literature there is data about arthritis, osteomyelitis, peritonitis, endocarditis, pneumonia, encephalitis and sepsis caused by Acremonium spp.4,7–16 In immunocompromised patients Acremonium spp. lung disease was observed in a few cases.17–19
The main risk factors for invasive fungal infections were prolonged neutropenia, allogeneic HSCT and graft-versus-host disease, primary immunodeficiency syndromes, prolonged stay in the ICU, peritoneal dialysis, etc.20–24 According to the data of Krcmery V et al.,22 up to 10% oncohematological patients with invasive mycosis suffer from Acremonium spp. Infection.22
It should be noted that the disease pattern in immunocompromised patients is similar to that in other invasive fungal infections. At the same time, it was noted and reflected in the published literature that if the risks of invasive fungal infections persist in the presence of the Acremonium spp. infection of the internal organs the fungemia develops rapidly.22–26
The high-resolution computed tomography is performed to determine the prevalence of pathological process in lungs, paranasal sinuses, abdominal organs. It should be noted that the CT signs of organ damage, for example in the lungs, are similar to those of other invasive fungal infections. Serologic diagnostic methods for Acremonium infection have not been developed yet.1–3,27
The main method that allows to diagnose invasive fungal infections caused by Acremonium spp. is mycological - identification of the causative agent in pathological material by microscopy, cultural and histological examination. It should be noted that the members of the Acremonium genus grow slowly; therefore, the Petri dishes should be viewed not less than 14days. Another method of diagnosis is pathomorphological study but identification of Acremonium spp. may be difficult, because the hyphae structure and branching in the tissues resemble Aspergillus spp.1,2,28 In the analyzed publications identification of the pathogen species failed in more than 50% of patients. Among the most frequently identified pathogens were Acremonium kiliense and Acremonium strictum (18% and 18%, respectively).2,29
Thus, the main criteria for the diagnosis of invasive fungal infections caused by Acremonium spp. in immunocompromised patients is identification the fungi of the genus Acremonium in mycological examination, combined with the presence of risk factors, clinical symptoms and instrumental examination data.
It should be mentioned that Acremonium spp. are resistant to many antifungals in vitro. According to the data of some researchers, certain species of Acremonium spp. can be susceptible to amphotericin B and some azoles.28–30 Fluconazole, flucytosine and echinocandins are not active against Acremonium.29,31 The first described cases reported about the use of amphotericin B, ketoconazole, fluconazole, itraconazole as antimycotic therapy. Further retrospective survival analysis showed that the use of liposomal amphotericin B and surgical treatment was prospective.29
Triazole antimycotics (voriconazole, posaconazole, and ravuconazole) exhibit different degrees of activity against Acremonium spp.30–32 According to the new international guidelines for the treatment of fungal infections caused by Acremonium spp. in immunocompromised patients with invasive process the drug of choice is voriconazole (AII).29 Surgical treatment (removal of the infection source) and removal/replacement of the central venous catheter also bring some success (CIII). Amphotericin B can be used in the absence of the first-line drugs (СII). The patients with lesions of the skin and soft tissues can also be treated with amphotericin B (BII) and its lipid fractions.29
Disease prognosis in immunocompromised patients depends on the clinical form and severity of the underlying disease. Survival rate in immunocompromised patients with local forms (lesions of the skin, soft tissues, bones, joints) is up to 100%; with invasive lesions of the internal organs - 75%; with acute disseminated process in the cases of early antimycotic therapy - about 50%.28,29
In the described clinical case the invasive pulmonary mycosis caused by Acremonium spp. in patient with acute myeloid leukemia was promptly diagnosed. Thus the empirical echinocandin therapy was replaced by a standard dose of voriconazole and at the same time the recovery of the granulocyte level was achieved. Adequate antimycotic therapy and stabilization of the underlying disease allowed to keep the patient alive.
In conclusion, acute myeloid leukemia, cytostatic chemotherapy and prolonged neutropenia are risk factors for invasive fungal infections caused by Acremonium spp. Combination of adequate antimycotic therapy and correction of risk factors is important for successful treatment of fungal infections.
None.
The author declares no conflict of interest.

©2016 Klimko, et al. This is an open access article distributed under the terms of the, which permits unrestricted use, distribution, and build upon your work non-commercially.